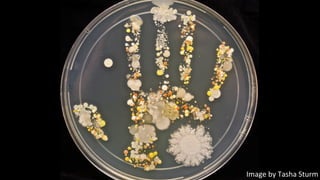

The document discusses why hand hygiene is important in healthcare settings but is often not properly practiced. It provides background on healthcare-associated infections, noting they affect 10% of hospitalized patients and are a major cause of death. Poor hand hygiene allows harmful bacteria like Streptococcus pyogenes to spread. While handwashing guidelines exist, complex barriers like lack of evidence, poor design of facilities, and lack of focus and feedback prevent adherence. A major factor is culture - role models who prioritize hand hygiene can influence others to make it a consistent practice and save lives.